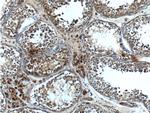
CIAO1 Antibody in Immunohistochemistry (Paraffin) (IHC (P))

Search
Proteintech
CIAO1 Polyclonal Antibody
{{$productOrderCtrl.translations['antibody.pdp.commerceCard.promotion.promotions']}}
{{$productOrderCtrl.translations['antibody.pdp.commerceCard.promotion.viewpromo']}}
{{$productOrderCtrl.translations['antibody.pdp.commerceCard.promotion.promocode']}}: {{promo.promoCode}} {{promo.promoTitle}} {{promo.promoDescription}}. {{$productOrderCtrl.translations['antibody.pdp.commerceCard.promotion.learnmore']}}
产品信息
10295-1-AP
种属反应
宿主/亚型
分类
类型
抗原
偶联物
形式
浓度
规格
纯化类型
保存液
内含物
保存条件
运输条件
产品详细信息
10295-1-AP detected 48-55 kDa band because of phosphorylation. 10295-1-AP does well in IHC and IF detection.
Immunogen sequence: MKDSLVLLG RVPAHPDSRC WFLAWNPAGT LLASCGGDRR IRIWGTEGDS WICKSVLSEG HQRTVRKVAW SPCGNYLASA SFDATTCIWK KNQDDFECVT TLEGHENEVK SVAWAPSGNL LATCSRDKSV WVWEVDEEDE YECVSVLNSH TQDVKHVVWH PSQELLASAS YDDTVKLYRE EEDDWVCCAT LEGHESTVWS LAFDPSGQRL ASCSDDRTVR IWRQ (1-223 aa encoded by BC001395)
靶标信息
WDR39 is a member of the WD40 family of proteins. WDR39 specifically interacts with WT1 both in vitro and in vivo. This interaction results in a decrease in transcriptional activation mediated by WT1. WDR39 does not inhibit binding of WT1 to its consensus nucleotide sequence and does not affect the repression activity of WT1. Thus, WDR39 appears to specifically modulate the transactivation activity of WT1 and may function to regulate the physiological functions of WT1 in cell growth and differentiation.
仅用于科研。不用于诊断过程。未经明确授权不得转售。
篇参考文献 (0)
生物信息学
蛋白别名: CIAO1; cytosolic iron-sulfur protein assembly 1 homolog; Probable cytosolic iron-sulfur protein assembly protein CIAO1; unnamed protein product; WD repeat domain 39; WD repeat-containing protein 39; WD40 protein Ciao1
基因别名: CIA1; CIAO1; MMDS10; WDR39
UniProt ID: (Human) O76071
Entrez Gene ID: (Human) 9391